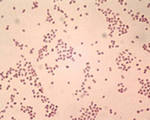
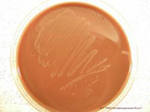

Гонорея – это одно из наиболее распространенных
венерических заболеваний. В настоящее время данным заболеванием болеют порядка 200 миллионов жителей земли. На фоне активного применения
антибиотиков и бактерицидных препаратов частота осложнений значительно снизилась. Но при этом, нерациональное лечение антибактериальными препаратами и несвоевременное лечение привели к тому, что растет удельный вес хронических и бессимптомных форм заболевания. Следует отметить, что гонорея в подавляющем большинстве случаев передается половым путем, потому распространенность этого заболевания тесно связано с культурой сексуального поведения различных социальных групп.
Как передается гонорея, какие органы поражает?
Многолетние исследования подтвердили преимущественный половой путь передачи инфекции.
Половой путь передачи инфекции Имеет место при любом виде полового контакта: генитальном, оральном, анальном. Однако, в зависимости от способа заражения, клиническая картина гонореи будет различной. Инфицирование возможно при половом контакте с больным или с носителем инфекции.
Вертикальный путь передачи инфекции (от матери плоду) Внутриутробного инфицирования плода при гонореи не наблюдается, однако инфицирование околоплодных вод при беременности на фоне гонореи возможно. Чаще инфицирование ребенка происходит при продвижении плода по родовым путям женщины. Наиболее уязвимыми в этом случае будут глаза новорожденного. При поражении глаз развивается специфический конъюнктивит – гонобленорея. Если при этой патологии своевременно не начать лечение, то ребенок может потерять зрение.
Бытовой путь передачи Возможен при использовании одного полотенца, постельного белья или нижнего белья. Однако оставаться во внешней среде жизнеспособными гонококки могут лишь ограниченное несколькими минутами время.
Учитывая половой путь передачи гонорейной инфекции, естественным является поражение преимущественно половых органов и находящихся рядом мочевыделительных.
Для женщин характерен гонококковый
цервицит (воспаление слизистой шейки матки) и
уретрит (воспаление мочеиспускательного канала),
цистит (воспаление мочеиспускательного канала).
Среди инфицированных мужчин чаще встречается гонококковый уретрит, простатит,
орхит,
эпидидимит.
Среди лиц обоих полов одинаково часто встречается гонококковый
фарингит.
Среди новорожденных чаще встречается гонорейный
конъюнктивит.
Симптомы гонореи у мужчин
| Гонорейный уретрит - воспаление мочеиспускательного канала | Наиболее частым симптомом является воспаление мочеиспускательного канала - Воспаление сопровождается рядом симптомов:
- Жжение, усиливающееся при мочеиспускании
- Воспаление слизистой мочеиспускательного канала
- Болезненность при мочеиспускании
- Обильные или не очень гнойные выделения бледно-желтого цвета
| ![]() |
| Простатит – воспаление предстательной железы | Как правило, возникает спустя несколько дней с момента дебюта гонококкового уретрита. Гонококковая инфекция достигает тканей простаты восходящим путем по мочеиспускательному каналу. Простатит характеризуется рядом симптомов:
- Болезненность в области промежности
- Резкая болезненность при ощупывании простаты через задний проход
- Нарушение эрекции
|
Подпишитесь на Здоровьесберегающий видеоканал


Симптомы гонореи у женщин
| Симптомы гонореи у женщин, как правило, проявляются во время ближайшей от момента инфицирования менструации. Чаще это заболевание проявляется симптомами вульвовагинита и уретрита. |
| Гонорейный уретрит - воспаление мочеиспускательного канала | Гонококковый уретрит обладает рядом схожих с уретритом у мужчин симптомами:
- Жжение, усиливающееся при мочеиспускании
- Воспаление слизистой мочеиспускательного канала
- Болезненность при мочеиспускании
- Обильные или не очень гнойные выделения бледно-желтого цвета
| ![]() |
| Вульвовагинит - воспаление слизистой вульвы и влагалища | Чаще проявляется спустя несколько дней после инфицирования или в период менструации. Признаки характерные для гонококкового вульвовагинита:
- Воспаление слизистой половых губ, влагалища и наружного зева мочеиспускательного канала.
- Выраженный зуд в промежности
- Обильные или не очень выделения бледно-жетоватой окраски и консистенции сливок.
- Болезненность при половом генитальном контакте
|
Осложнения гонореи
Как правило, своевременное и адекватно проведенное лечение приводит к полному выздоровлению пациента. Однако в ряде случаев инфекционный процесс может прогрессировать, продвигаясь восходящим путем по мочевыводящим и половым путям. В этом случае возникают поражения соответствующих органов, что может угрожать жизни, детородной способности и здоровью пациента.
Среди женщин возможно развитие таких осложнений как: ![]() Гонорейный бартолинит
Гонорейный бартолинит – воспаление бартолиновой железы расположенной в задней трети больших половых губ и имеющих выводные протоки, открывающиеся во внешнюю среду у основания больших половых губ. Их воспаление сопровождается резкой болезненностью, выраженной воспалительной реакцией и отечностью соответствующей области.
Гонококковый эндометрит – продвижение гонококковой
инфекции в восходящем направлении по половым путям может привести к инфицированию слизистой матки. Это осложнение может сопровождаться болезненностью в нижней части живота, обильными кровянистыми и гнойными выделениями из половых путей, резким повышением температуры тела. Это состояние требует немедленного обращения за помощью к врачу гинекологу, так как оно угрожает жизни пациентки.
Гонорея маточных труб – при продвижении инфекции из полости матки в просвете маточных труб возникает воспаление слизистой маточных труб. Данный процесс сопровождается болезненностью в нижней области живота, болезненностью при половом контакте,
бесплодием и нарушением
менструального цикла.
Гонорейный перитонит – воспаление тазовой брюшины возможно при проникновении гонококков в брюшную полость. Данное состояние сопровождается выращенным подъемом температуры тела, болями в нижней части живота. При
УЗИ исследовании выявляется наличие жидкости и могут визуализироваться абсцессы в тазовой полости.
При воспалительном процессе в женских половых органах малого таза возможно развитие бесплодия. Это может быть вызвано рядом факторов: формирование спаек в тазовой брюшине, трубная непроходимость, хроническое воспаление эндометрия матки, нарушение менструального цикла.
При возникновении любого из вышеперечисленных осложнений лечение возможно лишь в условиях стационара под наблюдением лечащего врача гинеколога. К сожалению, при любом из перечисленных осложнений (крове гонококкового
бартолинита) высока вероятность развития женского бесплодия.
Среди мужского населения инфицированного гонореей возможны следующие осложнения: Эпидидимит – воспаление придатка яичка. Этот придаток является расширенным семявыносящим канальцем, в котором накапливается сперма перед выведением ее во время эякуляции.
Воспаление семявыносящих каналов может приводить к их последующей обструкции и развитию мужского бесплодия.
Лабораторная диагностика гонореи
Экспресс-тест, микроскопия мазка, реакция иммунной флуоресценции (РИФ), иммуноферментный анализ (ИФА), реакция связывания комплемента (реакция Борде-Жангу), полимеразная цепная реакция (ПЦР), лигазная цепная реакция (ЛГЦ), культуральный метод, провокационные пробы. Особенности гонококка ![]() Гонорея или триппер
Гонорея или триппер является одним из самых распространенных венерических заболеваний на планете. Гонорея вызывается особой бактерией –
гонококком. Гонококк является кислотоустойчивым микроорганизмом, то есть его клеточная стенка способна защитить его от воздействия нормальной кислой среды половых путей женщины. Особенность клеточной стенки гонококка такова, что он способен формировать антитела различного класса в крови (IgG, IgM, IgA). Причем гонококк формирует особое состояние организма человека, при котором повторное инфицирование происходит легче, чем первое. Высокие титры антител против гонококковой инфекции могут сохраняться в крови достаточно длительное время.
Гонорея может быть острой и хронической. Хронизация острой гонококковой инфекции происходит при неполноценном функционировании иммунной системы. С точки зрения диагностики большую сложность представляет собой выявление хронической гонореи. Следует помнить, что в последние годы гонорея часто протекает, скрыто, имеется множество устойчивых форм. В данной ситуации качественная и всесторонняя лабораторная диагностика гонореи играет неоценимую роль. В настоящее время для диагностики гонореи наиболее широко используются методы микроскопического исследования мазка, культуральный и реакция иммунофлуоресценции. Все более широко используется и метод полимеразной цепной реакции.
Итак, рассмотрим, основные виды лабораторной диагностики, которые применяют в настоящее время для диагностики гонореи.
Методы, которыми возможно идентифицировать гонококк:
- экспресс-тесты (иммунохимические методы встречного электрофореза)
- бактериологический (культуральный, бактериологический посев)
- микроскопия мазка отделяемого мочеполовых органов
- реакция иммунной флуоресценции (РИФ)
- иммуноферментный анализ
- серологический метод (реакция Борде-Жангу или реакция связывания комплемента)
- методы молекулярно-генетической диагностики (лигазная цепная реакция, полимеразная цепная реакция)
- провокационные пробы (для обнаружения хронической инфекции)
Экспресс-тесты – чувствительность, специфичность, достоинства и недостатки метода
![]()
Экспресс-тесты просты, их можно применять дома в экстренном случае. Внешне похожи на тест для определения беременности. Чтение результатов происходит точно также: одна полоска – результат отрицательный (нет гонорейной инфекции), а две полоски – результат положительный (наличие гонорейной инфекции). Экспресс-тесты на гонорею довольно чувствительны и специфичны. При этом используется метод встречного электрофореза. При проведении такого встречного электрофореза происходит слияние антигенов гонококка и антител, содержащихся в специальной сыворотке. В результате образуется комплекс антиген + антитело, который окрашивает вторую полоску экспресс-теста.
Однако полностью положиться на результат таких экспресс-тестов не стоит, поскольку может образоваться комплекс антиген + антитело не с гонококком, а с другим похожим микроорганизмом. В этом случае получится положительный результат, а гонореи нет. Или в обратном случае, когда концентрация комплексов антиген + антитело будет слишком мала, и результат будет отрицательным, а гонорея присутствует. В случае возникновения подозрения на заражение гонореей следует пройти обследование с применением более точных методов диагностики.
Микроскопия мазка отделяемого мочеполовых органов – чувствительность, специфичность, достоинства и недостатки метода
Как и когда правильно взять мазок? Способы окраски мазка ![]()
Для исследования под микроскопом производят забор отделяемого мочеиспускательного канала, влагалища, канала шейки матки, прямой кишки. При этом перед забором биологического материала необходимо прекратить прием антибиотиков минимум за 4-5 дней, в течение 3-4 часов перед забором проб воздержаться от мочеиспускания. Мазки берут в двух экземплярах. Первые экземпляры данных мазков окрашивают метиленовым синим, бриллиантовым зеленым. Наиболее распространен метод окраски метиленовым синим. При этом гонококки окрашиваются в интенсивно синий цвет на фоне бледно-голубой цитоплазмы лейкоцитов. Гонококки могут находиться внутри лейкоцитов или снаружи. Окраска бриллиантовым зеленым дает более сильный контраст между лейкоцитами и гонококками, окрашивая более интенсивно гонококки. Оба этих вида окраски служат ориентировочными, выявляя кокки вообще. Поэтому после выявления кокков, в мазке, окрашенном метиленовым синим, или бриллиантовым зеленым, проводят окраску второго экземпляра мазка по способу Грама. В результате такого метода гонококки окрашиваются в ярко-розовый цвет. Диагноз гонореи ставится только при обнаружении гонококков в мазке, окрашенном по Граму. Окраска метиленовым синим применяется для лучшего выявления кокков, а окраска по Граму применяется для дифференцировки именно гонококков.
Чувствительность, специфичность метода. Достоинства и недостатки ![]()
Чувствительность данного метода очень вариабельна и составляет 40-86%. Такой разброс связан с тем, что имеются различные подвиды гонококков, некоторые из которых не окрашиваются данным методом. Специфичность же метода довольно высока и доходит до 92%. Также при изучении окрашенных мазков под микроскопом решающее значение имеет квалификация врача-лаборанта. Данный метод является широко распространенным ввиду его доступности, простоты, быстроты и дешевизны.
При выявлении гонококков в мазке, окрашенном по Граму, проведение иных методов диагностики нецелесообразно. Можно провести бактериологический посев с целью выявления чувствительности к антибиотикам.
Бактериологический метод (культуральный) – чувствительность, специфичность, достоинства и недостатки метода
![]()
Бактериологический или культуральный метод принято считать «золотым стандартом» в выявлении различных инфекционных заболеваний, в том числе гонореи. Суть данного метода состоит в том, что отделяемое слизистых мочеполового тракта высевают на специальные питательные среды и помещают в инкубатор с условиями, пригодными для роста колоний гонококка (высокое содержание углекислого газа 20-23%, температура 37° С). Используется специальная среда, на которой лучше всего растет именно гонококк. Спустя некоторое время (3-7 суток) проверяют выросли ли колонии гонококка. Если колонии выросли, то это является несомненным результатом наличия гонококковой инфекции в организме. Огромный плюс данного метода практически стопроцентная специфичность и отсутствие ложноположительных результатов. Ложноположительный результат – это такой результат, при котором выявлены микроорганизмы там, где их нет. Чувствительность культурального метода также высока и варьирует в пределах 90-98%.
На сегодняшний день применяют стандартизированные среды, которые дают прекрасные результаты. Определенным минусом культурального метода является его длительность. Однако длительность окупается точностью, что особенно важно при выявлении хронической персистирующей инфекции.
Реакция иммунной флуоресценции (РИФ) – чувствительность, специфичность, достоинства и недостатки метода
![]()
Реакция иммунной флуоресценции требует тщательной подготовки персонала, наличия флуоресцентного микроскопа и качественных реактивов. При проведении данного метода также берется мазок со слизистых мочеполового тракта и окрашивается специальными красителями, которые флуоресцируют (светятся) под микроскопом. Точность окрашивания именно гонококков достигается иммунной реакцией красителя, содержащего антитела к гонококку. То есть антитела, меченные красителем, связываются с антигенами на поверхности гонококка и образуют иммунные комплексы. Эти иммунные комплексы видны под микроскопом в виде светящихся кругов. Метод реакции иммунной флуоресценции позволяет выявить гонорею на ранней стадии заболевания, а также выявить именно гонорею, если она протекает совместно с другими инфекциями мочеполового тракта (например,
сифилисом или
трихомониазом). Реакция иммунной флуоресценции чувствительна в отношении гонококка – 75-80% и высокоспецифичная. Однако применение данного метода ограничено небольшим количеством специалистов, а также дороговизной оборудования и реактивов. При этом метод иммунной флуоресценции позволяет провести исследование в течение 1 часа, что является его несомненным преимуществом.
Иммуноферментный анализ (ИФА) – чувствительность, специфичность, достоинства и недостатки метода
Иммуноферментный анализ для выявления гонококка не является широко распространенным. Данный метод имеет преимущество и недостаток одновременно. В ходе иммуноферментного анализа выявляют наличие антител к гонококку. При этом возможно выявление уже мертвого возбудителя, который еще находится в организме, так как его не успели элиминировать лейкоциты. При этом получится положительный результат, так как метод не умеет отличать мертвые гонококки от живых. В этом состоит минус иммуноферментного анализа для выявления гонококков. А плюсом является способность метода выявлять наличие устойчивых форм гонококка, которые трудны для диагностики. Также к неоспоримым преимуществам метода относится его неинвазивность, то есть отсутствие необходимости брать мазки, поскольку иммуноферментный анализ проводится в пробе мочи. Чувствительность иммуноферментного анализа для выявления гонореи составляет 95%, а специфичность – 100%. Однако на сегодняшний день иммуноферментный анализ используется как вспомогательный метод диагностики в большинстве случаев.
Серологический метод (реакция связывания комплемента, реакция Борде-Жангу) – чувствительность, специфичность, достоинства и недостатки метода
Из всего многообразия серологических методов для выявления гонококка применяется только реакция связывания комплемента (РСК), которая применительно для гонореи носит имя своего разработчика – реакция Борде-Жангу. На сегодняшний день метод является вспомогательным, однако имеет неоценимое значение в выявлении хронической гонореи, при которой культуральный метод дает отрицательные результаты. Именно в таких редких случаях применяют реакцию Борде-Жангу для диагностики гонореи.
Методы молекулярно-генетической диагностики – чувствительность, специфичность, достоинства и недостатки метода Какие методы относят к молекулярно генетическим? К таким методам относят полимеразную цепную реакцию и лигазную цепную реакцию. Особенность всех методов молекулярно-генетической диагностики в их исключительно высоких чувствительности и специфичности. Однако проведение данных методов диагностики является сложным, высокотехнологичным, требует специализированных лабораторий и высококвалифицированного персонала. Итак, рассмотрим каждый метод подробнее.
Полимеразная цепная реакция (ПЦР)
Чувствительность метода достигает 99%, а специфичность – 95%. В качестве биологического материала для полимеразной цепной реакции могут быть использованы отделяемое слизистых мочеполового тракта, а также пробы мочи. Полимеразная цепная реакция – это высокоточный метод диагностики, который способен составить конкуренцию даже «золотому стандарту» - культуральному методу. Преимуществом полимеразной цепной реакции также является возможность одновременного определения наличия гонококков и
хламидий в одном и том же биологическом образце. Метод полимеразной цепной реакции более быстрый по сравнению с культуральным. Однако ПЦР-диагностика довольно дорога, что связано с дорогими реактивами, необходимыми для проведения реакции и сложным дорогостоящим оборудованием.
Лигазная цепная реакция
Чувствительность лигазной цепной реакции превышает таковую у полимеразной цепной реакции, а специфичность доходит до 99%. Лигазная цепная реакция превосходит по своим характеристикам культуральный метод, однако не имеет столь широкого распространения. Это связано с тем, что требуется специально оборудованные лаборатории, высококвалифицированный персонал и реактивы. На сегодняшний день лигазная цепная реакция проводится даже не во всех крупных центрах. Однако ценность ее очень высока. Лигазная цепная реакция также позволяет выявлять одновременно гонококк и хламидию в одном биологическом образце. Длительность лигазной цепной реакции такая же, как у полимеразной цепной реакции, то есть минимум 3-4 часа, максимум 7-8 часов (в зависимости от оборудования). В качестве биологической пробы также возможно использование мочи или мазка со слизистых мочеполового тракта.
Провокация гонореи - пробы для выявления хронической гонококковой инфекции
В каких случая необходимо проведение провокационных проб? В случаях, когда гонорейная инфекция запущена, подвергалась неадекватному лечению или многократному лечению с использованием антибиотиков, одним словом, когда имеет место хронизация процесса, возникают сложности в диагностике гонореи. В таких случаях гонококк приобретает плотную клеточную стенку, которая называется
циста, и уходит в глубокие слои мочеполового тракта (вплоть до мышечного слоя). Внутри клеток глубоких слоев мочеполового тракта в таком состоянии цисты гонококк способен жить долгое время, а при благоприятных для него условиях вновь выходить на слизистые и вызывать рецидив гонореи. Течение таких хронических гонорей является очень длительным и упорным, а мазок или соскоб не выявляет наличие микроорганизма, поскольку гонококк спрятан в глубине тканей мочеполовых путей.
Чтобы вызвать появление гонококка на слизистых оболочках мочеполового тракта, если он присутствует в организме в виде цисты, и используют провокационные тесты. Провокация способствует выходу гонококка на слизистые оболочки мочеполового тракта, и тогда его можно выявить в мазке или бактериологическом посеве.
| Типы провокационных тестов | Способы проведения |
| химическая провокация | При этом производят смазывание уретры1—2% раствором нитрата серебра, прямой кишки 1% раствором Люголя в глицерине и цервикального канала (канала шейки матки)2—5% раствором нитрата серебра. По прошествии от момента проведения провокации одних суток (24 часа) берут соскоб-мазок отделяемого слизистых уретры, цервикального канала и прямой кишки. Такие соскобы-мазки со слизистых оболочек берут через 48 и 72 часа после проведения провокации. Через трое суток после проведения провокации (72 часа) также производят бактериологический посев отделяемого слизистых мочеполового тракта. Во всех соскобах-мазках микроскопически выявляют наличие или отсутствие гонококка. Бактериологический посев позволяет выявить наличие микроорганизма, и его чувствительность к антибиотикам. |
| биологическая провокация | Суть данного вида провокации заключается во введении гонококковой вакцины внутримышечно или одновременно вводится гонококковая вакцина в сочетании со стимулятором иммунной системы – пирогеналом. После проведения такой провокации также берут мазки-соскобы через 24, 48 и 72 часа от момента проведения теста. Через 72 часа после момента введения биологических провокаторов берется бактериологический посев. В мазках-соскобах и бактериологическом посеве выявляют наличие или отсутствие гонококков. |
| термическая провокация | В ходе термической провокации проводится физиологическая процедура диатермии или индуктотермии. При этом диатермия проводится в течение трех дней подряд по следующей схеме – 30 минут в 1-й день, 40 минут во 2-й день, 50 минут в 3-й день. Индуктотермия также проводится в течение трех дней подряд по 15—20 минут ежедневно. Соскобы-мазки отделяемого слизистых мочеполового тракта для бактериологического исследования под микроскопом берут ежедневно через 1 час после проведения физиотерапевтической процедуры диатермии или индуктотермии. |
| физиологическая провокация | Не требует никакой специальной подготовки и использует взятие мазков в дни менструации. Данная провокация является естественной, потому что в период менструации происходит снижение иммунной защиты организма женщины. |
| алиментарная провокация | Данный вид провокации основан на употреблении соленой, пряной пищи совместно с алкоголем. Приветствуется прием несовместимых продуктов (например, соленые огурцы с молоком и пивом и т.д.) для максимальной информативности провокации. При этом после проведения провокации берутся соскобы-мазки через 24,48 и 72 часа и бактериологический посев через 72 часа, считая от момента проведения теста – провокации. |
| комбинированная провокация | Включает в себя проведение двух или нескольких провокационных проб в течение одного дня. Соскобы-мазки и бактериологический посев проводятся также как и при проведении каждой пробы в отдельности. То есть отделяемое слизистых мочеполового тракта берётся через 24, 48 и 72 часа, а бактериологический посев отделяемого проводится через 72 часа после проведения комбинированной пробы. |
Лечение гонореи
![]()
Гонорея – это инфекционное заболевание, потому и лечение основано на применении антибактериальных препаратов.
Основные принципы лечения гонореи:
- Адекватное лечение возможно лишь под наблюдением лечащего врача гинеколога, уролога или венеролога.
- Лечению должна предшествовать полноценная диагностика, включающая и проведение лабораторных анализов (микроскопические, бактериологические исследования мазка), инструментальных исследований (УЗИ органов малого таза для исключения возможных осложнений).
- Перед назначением лечения гонореи необходимо провести лабораторные исследования на другие венерические заболевания – хламидиоз, сифилис, микоплазма, уреаплазма. Как правило, в наше время редко встречается инфицирование одним лишь венерическим заболеванием – чаще диагностируется букет из нескольких инфекций. Лишь выявив все сопутствующие инфекции у лечащего врача появится возможность назначения адекватного лечения.
- Самостоятельно начинать лечение, вносить свои изменения в схему лечения и его длительность, равно как и прерывать его нельзя. Это может привести к развитию хронической гонореи нечувствительной к некоторым видам антибиотиков.
- Лечение должно сопровождаться диагностикой гонореи у всех половых партнеров.
- В период лечения любые половые контакты должны быть исключены.
- После проведенного лечения обязателен лабораторный контроль излеченности. Лишь это исследование может подтвердить или опровергнуть факт выздоровления. Отсутствие гнойных выделений или признаков воспаления не означает выздоровление пациента.
Лечение антибиотиками
Мы предоставляем стандартные схемы, применяемые в лечении свежей гонореи: - Цефтриаксон по 0,25 г. Однократно
или
- Ципрофлоксацин 0,5 г. Внутрь однократно
или
- Офлоксацин 0,4 г. Внутрь однократно
или
- Ломефлоксацин 0,6 г. Внутрь однократно
Лечение хронической и латентных форм гонореи: Применению антибиотиков должно предшествовать применение специальной вакцины, которую вводят внутримышечно. Данная вакцина содержит фрагменты гонококков и способствует формированию специфического иммунитета к гонококковой инфекции.
Вакцина вводится курсами по 6-8-10 инъекций с разовой дозировкой в 300-400 млн. микробных тел и суммарной курсовой дозировкой в 2 миллиарда микробных тел.
Наряду с вакцинацией производится неспецифическая симуляция иммунитета при помощи медикаментозных препаратов: пирогенал, стрептокиназа, рибонуклеаза.
После стимуляции иммунитета и проведения провокации возможно назначение антибактериальных препаратов согласно стандартным схемам лечения.
Лечение гонореи при беременности Состояние беременности накладывает ряд ограничений в использовании иммуностимулирующих и антибактериальных препаратов. Однако предпочтение в лечении в данном случае отдается следующим антибиотикам: цефтриаксон, эритромицин, спектриномицин, хлорамфеникол.
Лечение беременных возможно лишь под строгим наблюдением лечащего врача гинеколога.
Профилактика гонореи
Единственным надежным средством профилактики гонореи является сексуальные контакты с партнерами, у которых диагностика подтвердила отсутствие данного заболевания или использование презерватива. В том случае, если данные условия не соблюдаются, то вероятность инфицирование гонореей при каждом новом половом контакте сохраняется.
Среди беременных женщин подготовка к родам включает исследование на наличие венерически заболеваний.
Так же всем новорожденным после рождения закапываются антисептические препараты уничтожающие гонококк. Эти меры позволяют минимизировать инфицирование новорожденного.
Использование индивидуальных средств гигиены, нижнего белья и полотенца позволит исключить бытовой путь инфицирования.
Сколько длится лечение гонореи?
![]()
Гонококковая инфекция, или гонорея, является заболеванием, которое имеет различные клинические формы. Поэтому однозначно ответить, сколько будет длиться лечение пациента довольно сложно. Это зависит от целого ряда различных факторов. В зависимости от особенностей течения болезни у конкретного пациента лечение может сводиться к однократной инъекции антибиотика либо тянуться в течение нескольких месяцев.
Основными факторами, влияющими на длительность лечения, являются: - Особенности возбудителя. Каждый микроорганизм, как и каждый человек, имеет свои уникальные особенности. В частности, среди микроорганизмов различают штаммы с различной чувствительностью к антибиотикам. Если микроб вступал в контакт с определенным препаратом, но не был уничтожен, то высока вероятность, что в дальнейшем он уже не будет восприимчив к такому же лечению. Такие штаммы называются антибиотикорезистентными. В настоящее время среди гонококков они составляют от 5 до 30% всех случаев, в зависимости от местности (страны, города). Таким образом, лечение чувствительного штамма будет длиться меньше, чем резистентного. Далеко не всегда врачи назначают анализ на чувствительность к определенным препаратам (антибиотикограмму). Из-за этого первый курс лечения антибиотиком может оказаться неэффективным, и лечение затянется.
- Локализация инфекции. В большинстве случаев гонорея протекает в виде гонококкового уретрита (воспаление мочеиспускательного канала). В этом случае ее лечение будет состоять в разовой инъекции цефтриаксона или цефотаксима (реже других препаратов). У более чем 95% пациентов этого достаточно для полного излечения. Если же гонококковая инфекция локализуется в нетипичных местах (слизистая оболочка анального отверстия, глотка, конъюнктива глаз), то наряду с системным применением антибиотика потребуется и местное. Тогда лечение может затянуться. Наиболее тяжело поддается лечению диссеминированная гонококковая инфекция, когда возбудитель попадает в кровь и разносится по различным органам.
- Соблюдение предписаний врача. При гонорее данный фактор имеет огромное значение. Дело в том, что прерывание лечения без лабораторного подтверждения излечения может привести к серьезным последствиям. Во-первых, инфекция способна приобретать хроническое течение. После этого придется искусственно вызывать обострение, чтобы ее вылечить. Во-вторых, у штамма микробов данного пациента может развиться устойчивость к препарату, которым было начато лечение. Тогда в будущем для повторного курса придется подбирать новый антибиотик. Наконец, в-третьих, пациент, который считает, что выздоровел, начинает вести активную половую жизнь. Это приводит к заражению его половых партнеров. В результате инфекция циркулирует по замкнутому кругу, и избавиться от нее становится еще сложнее.
- Наличие других инфекций. Часто гонорея сочетается с урогенитальным хламидиозом или трихомониазом. Это объясняется тем, что первая инфекция ослабляет защитные ресурсы слизистой оболочки и как бы «открывает ворота» для второй. Для полного излечения, соответственно, требуется более длительный курс антибиотиков.
- Наличие осложнений. Иногда гонорея не проявляется острыми симптомами, но со временем приводит к ряду неприятных осложнений. У мужчин это баланопостит, острый и хронический простатит, а у женщин – гонококковый бартолинит и сальпингит. Эти осложнения, как правило, усложняют процесс лечения и пациенту приходится тратить на него больше сил и времени.
- Состояние организма. У пациентов с ослабленным иммунитетом, а также у женщин во время беременности гонококковая инфекция может протекать агрессивнее. Она быстрее и легче распространяется, чаще сопровождается осложнениями. Из-за этого лечение таких пациентов, как правило, длится дольше.
В среднем, если брать за начало отсчета момент обращения к врачу, лечение длится 1 – 2 недели. Подтверждение факта выздоровления проводится с помощью микробиологического анализа. У мужчин его делают через 7 – 10 дней после окончания курса антибиотиков, а у женщин – также через неделю, а потом повторно, после второго менструального цикла. Это позволяет исключить наличие хронических форм инфекции. При экстрагенитальных формах гонореи лечение может затянуться до нескольких месяцев, а убедиться в полном выздоровлении значительно труднее.
Чтобы максимально сократить срок лечения гонореи, независимо от ее формы, нужно соблюдать несколько простых правил: - соблюдение предписаний врача относительно приема антибиотиков (сроки, дозы, кратность применения);
- одновременное обследование и лечение всех половых партнеров пациента;
- воздержание от половых контактов до проведения контрольного бактериологического анализа;
- обследование на другие инфекции.
Отдельно следует сказать о лечении гонококкового конъюнктивита у новорожденных. Если не была проведена специальная профилактика этого заболевания, приходится применять не только антибиотики, но и делать локальные промывания глаз антисептическими препаратами. Такое лечение длится в среднем несколько недель, а факт выздоровления подтверждается не только лабораторно, но и врачом-офтальмологом после специального обследования.
Можно ли заниматься любовью во время лечения гонореи?
![]()
Как известно, гонококковая инфекция, или гонорея, чаще всего поражает мочеполовую систему. У мужчин она обычно вызывает передний или задний уретрит (
воспаление мочеиспускательного канала), а у женщин также
вульвовагинит. Кроме того, гонорея является очень заразной инфекцией, которая легко передается при половом контакте. Она не оставляет после излечения иммунитета, поэтому человек легко может повторно заболеть. Исходя из этого, в период лечения гонореи больной должен воздержаться от любых половых контактов, так как это может привести к серьезным последствиям.
Половые контакты в период лечения опасны по следующим причинам: - Распространение инфекции. До окончания курса лечения и проведения контрольных анализов пациент представляет угрозу в плане распространения инфекции. Несмотря на то, что для выздоровления зачастую хватает 1 инъекции антибиотика, ни один врач не может сказать наверняка, излечена ли гонорея после этого. Таким образом, есть шанс, что больной попросту заразит своего полового партнера. Это опасно еще и тем, что после окончания лечения (получения отрицательного результата контрольного анализа) он может повторно вступить в контакт с этим партнером и снова заразиться. Таким образом, инфекция будет как бы циркулировать между двумя людьми. Если же у них более одного полового партнера, гонорея начнет распространяться в обществе.
- Повторное инфицирование. Реинфицирование опасно при половом контакте с партнером, который также болен гонореей. При этом пациент, находящийся на лечении, получает новую порцию бактерий. В отличие от собственных, погибающих под действием антибиотика, эти гонококки более сильны. Когда курс лечения закончится, они смогут снова размножиться, и выздоровление не наступит, хотя пациент прошел полный курс лечения. Кроме того, можно заразиться другим штаммом гонококков. Если он не будет восприимчив к начатому лечению, то придется заново повторять все анализы и менять препарат.
- Хронизация инфекции. Повторное инфицирование способствует хронизации инфекции. Если гонококки выживут после курса антибиотиков, они еще длительное время не будут давать о себе знать. Многие больные считают это достаточным подтверждением выздоровления и не проводят контрольный анализ. Тогда через некоторое время гонорея обострится вновь, ее лечение будет значительно более долгим и сложным, а также повысится риск осложнений.
- Развитие устойчивости к антибиотикам. Антибиотикорезистентность (устойчивость к определенным антибактериальным препаратам) является одной из основных проблем в современной медицине. Среди гонококков она регистрируется примерно в 5 – 15% случаев. Если больной в период лечения заразил полового партнера гонореей, то высока вероятность, что в будущем у его партнера разовьется болезнь, устойчивая к препарату, который был использован при лечении. Ведь микроорганизм уже контактировал с данным антибиотиком, а генетические перестройки у гонококков происходят достаточно быстро. В результате через некоторое время таким пациентам приходится тратить деньги на более сильные антибиотики, чтобы все же победить резистентный штамм и вылечиться.
- Развитие осложнений. Во время полового акта возможно распространение гонококковой инфекции не только на слизистую оболочку мочеполового тракта, но и на другие анатомические области. Как партнер пациента, так и сам пациент может в будущем дать ряд осложнений или нетипичных форм гонореи. Речь идет об аноректальной и фарингеальной гонорее. Кроме того, во время незащищенного полового акта часто появляются микротравмы слизистой оболочки. Через такие дефекты инфекция может попасть в кровь и разнестись по всему организму.
- Заражение другими инфекциями. В медицинской практике часто встречаются пациенты с несколькими сопутствующими мочеполовыми инфекциями. Их лечение требует более тщательного подбора препаратов, занимает больше времени и обходится значительно дороже. Половой контакт во время лечения гонореи может не только свести на нет само лечение, но и привести к «обмену» инфекциями. В результате пациент может заразиться хламидиозом, трихомониазом или другими распространенными болезнями.
Их этих соображений следует воздерживаться от половых контактов. Это не только убережет полового партнера от заражения, но и поспособствует скорейшему выздоровлению самого пациента. Презерватив в данном случае нельзя считать достаточной защитой, хоть инфекция и не может через него проникнуть. Дело в том, что у пациента могут быть и экстрагенитальные очаги (
не только в мочеполовом тракте). Тогда есть возможность заражения другим путем. Кроме того, никто не застрахован от разрывов
презерватива или от продукции низкого качества (
с микротрещинами).
Если половой контакт в период лечения все же имел место, об этом обязательно надо сообщить лечащему врачу. В этом случае может быть продлен курс лечения антибиотиками. Также могут потребоваться дополнительные анализы на другие мочеполовые инфекции. Полового партнера при этом находят, обследуют и начинают профилактическое лечение.
Безопасным секс становится только после проведения специального контрольного анализа. Он проводится на 7 – 10 день после окончания лечения. Если бактериологический посев не дает роста гонококков, и у пациента нет никаких симптомов болезни, его признают здоровым.
Можно ли забеременеть после гонореи?
![]()
Гонококковая инфекция у женщин чаще всего протекает без выраженных симптомов и локализуется в мочеиспускательном канале. Поэтому ни во время болезни, ни после окончания лечения ничего обычно не препятствует наступлению беременности. Детородные органы, как правило, не затронуты инфекцией. Тем не менее, в редких случаях возможно развитие ряда серьезных осложнений, которые могут отразиться на репродуктивной функции женщины. Прежде всего, речь идет о длительной хронической инфекции, лечению которой не уделяли достаточно времени.
Проблемы с зачатием ребенка после гонореи могут возникать в следующих случаях: - Неполное выздоровление. Гонококковая инфекция при неправильном лечении или преждевременном его прекращении может перейти в хроническую форму. При этом какие-либо симптомы болезни отсутствуют, но возбудитель все равно сохраняется на слизистой оболочке мочеполового тракта. Проблема в том, что его присутствие создает неблагоприятные условия внутри влагалища и матки. Шанс забеременеть снижается отчасти из-за недостаточного выделения смазки, отчасти – из-за малой подвижности и слишком быстрой гибели сперматозоидов после эякуляции (семяизвержения). Кроме того, возрастает шанс присоединения хламидиоза или трихомониаза, которые также понижают вероятность успешного оплодотворения. При этом никаких структурных изменений в мочеполовой системе может не наблюдаться. Обнаружение такой скрытой инфекции и полноценное лечение обычно возвращают репродуктивную функцию.
- Гонококковый сальпингит. Сальпингитом называется воспаление маточных труб. Оно может иметь место при остром течении инфекции с ярко выраженными симптомами. В период болезни могут появиться изменения в слизистой оболочке, выстилающей маточные трубы. В результате после курса лечения гонококковой инфекции больше нет, но проходимость маточных труб для яйцеклетки снижается. Чем более сильным был воспалительный процесс, и чем дольше игнорировалась болезнь, тем больше шанс потерять репродуктивную функцию. В тяжелых случаях изменения на уровне маточных труб оказываются необратимыми. Помимо стерильности возрастает риск внематочной беременности.
- Гонококковый пельвиоперитонит. Является наиболее тяжелым локальным осложнением гонококковой инфекции, при котором воспалительный процесс распространяется на брюшину малого таза. Тогда лечение может занять довольно много времени. За этот период чувствительная брюшина образует спайки. Это соединительнотканные мостики, которые не исчезают после стихания воспалительного процесса. Они деформируют органы, к которым крепятся, и нарушают их нормальную работу. Таким образом, после данного осложнения у женщины будет спаечная болезнь малого таза, которая в ряде случаев может проявляться бесплодием. Однако здесь проблему обычно можно решить путем хирургического рассечения спаек.
- Осложнения гонореи у полового партнера. Даже если женщина полностью излечилась от гонореи, это не значит, что болезни нет и у ее партнера. Мочеполовые инфекции обычно циркулируют между половыми партнерами, если не проводить одновременное лечение. У мужчин данное заболевание протекает, как правило, тяжелее. Без адекватного лечения возможно развитие простатита, гнойного уретрита, поражения желез и даже яичек (орхит). Тогда семенная жидкость по различным причинам может попросту не содержать сперматозоидов, либо они будут неспособны оплодотворить яйцеклетку.
Однако при отсутствии осложнений своевременный и квалифицированный курс лечения обоих партнеров приводит к полному выздоровлению. При этом репродуктивная функция не нарушается ни у мужчин, ни у женщин. Беременность лучше планировать примерно через полгода после сдачи контрольных анализов. За этот период репродуктивные органы войдут в нормальный режим работы (
восстановление регулярного менструального цикла, стабильная эрекция). Кроме того, антибиотики, принятые во время лечения, полностью выведутся из организма и никак не отразятся на процессе
зачатия или развития ребенка.
Какие выделения при гонорее?
![]()
Выделения из мочеиспускательного канала являются своеобразной «визитной карточкой» острой гонореи. Этот симптом отличает ее от большинства других мочеполовых инфекций и имеет очень большое диагностическое значение. При остром течении болезни именно характерные выделения помогают заподозрить правильный диагноз.
Выделения при гонорее имеют следующие характерные особенности: - У мужчин они появляются, как правило, через 1 – 5 дней после незащищенного полового контакта с инфицированным лицом. Иногда этот период затягивается до 30 дней (в зависимости от состояния иммунитета и особенностей возбудителя). При хроническом течении выделений может не быть в течение месяцев.
- У женщин выделения обычно более скудные даже при остром течении болезни.
- Внешне выделения имеют бело-желтый цвет. Без соответствующего лечения уже через несколько дней они становятся бело-зелеными, что говорит о примесях гноя.
- Чаще всего у мужчин выделения появляются в виде «утренней капли». Это симптом, при котором утром из отверстия на головке полового члена выделяется крупная капля слизисто-гнойной смеси. У женщин этот симптом отсутствует из-за другого анатомического расположения мочеиспускательного канала.
- При остром течении в мочеиспускательном канале образуется много гноя. Поэтому он может примешиваться к утренней порции мочи в виде хлопьев.
- При хроническом открытом течении выделения могут наблюдаться непрерывно в течение нескольких месяцев. При этом суточный объем небольшой – всего 1 – 2 небольшие капли.
- Выделения при гонорее имеют неприятный резкий запах, который появляется на 2 – 3 день после появления самого симптома. У женщин выделения могут быть не видны (например, в период менструации). Но сами менструальные выделения на фоне гонореи становятся более обильными и также приобретают неприятный запах.
- При остром течении болезни выделения могут наблюдаться и ночью. Это можно обнаружить по небольшим желтоватым пятнам на нижнем белье.
- Выделения из уретры (мочеиспускательный канал) усиливаются в определенных условиях. Таким провоцирующим фактором может стать алкоголь, острая пища, избыток кофеина, занятия сексом, медикаментозная провокация (бывает необходима для начала лечения при хроническом течении болезни).
- Выделения у мужчин почти всегда сопровождаются чувством жжения и умеренной болезненности.
- При отсутствии лечения выделения могут уменьшаться через 12 – 15 дней. Однако это порой говорит лишь о распространении инфекции вверх по мочеиспускательному каналу. Тогда у пациентов в конце акта мочеиспускания может выделяться 1 – 2 капли крови, иногда с примесями слизи и гноя. Это говорит о неблагоприятном течении болезни, риске осложнений и необходимости срочного начала лечения.
- В редких запущенных случаях как вариант выделений возможна гемоспермия – прожилки крови в семенной жидкости при эякуляции.
При экстрагенитальных формах гонококковой инфекции (
конъюнктивит, фарингит) выделения не так характерны. Они могут появляться в виде беловатого налета на
миндалинах или скапливаться по краям век у маленьких детей при бленнорее.
При хроническом скрытом течении болезни (
более характерном для женщин) выделений может не быть вообще. Однако это не значит, что болезнь исчезла или пациент идет на поправку. Под воздействием провоцирующих факторов, перечисленных выше, наступает обострение, и выделения появляются (
иногда в первый раз через месяцы после самого эпизода инфицирования).
Микроскопическое исследование выделений при гонорее показывает наличие следующих компонентов: - клетки эпителия;
- клетки возбудителя (Neisseria gonorrhoeae) – диплококки, расположенные внутри клеток эпителия;
- лейкоциты;
- слизь;
- эритроциты (редко, внешне выглядят как прожилки крови).
Посев выделений на питательные микробиологические среды всегда дает рост колоний возбудителя. Это и является основным подтверждением острой формы гонореи.
Можно ли вылечить гонорею в домашних условиях?
![]()
В принципе наиболее распространенная форма гонореи - гонококковый уретрит (
воспаление мочеиспускательного канала) вполне может быть излечен в домашних условиях. Однако лечение на дому не означает самолечение. Пациенту в любом случае обязательно надо посетить врача и сдать все необходимые анализы. В домашних условиях он может проходить непосредственно курс лечения, назначенный специалистом.
Для лечения гонореи в домашних условиях необходимо пройти следующие этапы: - Консультация врача дерматовенеролога. Специалист по симптомам может заподозрить гонорею и назначить соответствующие лабораторные анализы. Сам пациент, основываясь лишь на собственных жалобах, может спутать гонорею с другой мочеполовой инфекцией.
- Лабораторные анализы. Как правило, врач берет мазок со слизистой оболочки уретры. Впоследствии полученный материал засевают на питательные среды в микробиологической лаборатории. Получение культуры гонококка подтверждает диагноз. При необходимости врач берет также мазок со слизистой оболочки прямой кишки, конъюнктивы или глотки. При выраженных общих симптомах (температура, общая слабость и др.) на анализ берется и кровь пациента. Так определяется клиническая форма заболевания.
- Лечение на дому. Если гонококковая инфекция локализуется только в мочеиспускательном канале, врач назначает необходимый антибиотик. Чаще всего необходима лишь одна доза (инъекция или таблетка). Реже курс длится 1 – 2 недели. Самостоятельно пациент обрабатывает слизистую оболочку и кожу дезинфицирующими растворами (инсталляции в уретру у мужчин, в полость влагалища у женщин). В этом случае госпитализация не требуется.
- Контрольный анализ. Через 7 – 10 дней после окончания лечения антибиотиками пациент сдает мазок еще раз. Если результат отрицательный, его признают здоровым. Женщинам может понадобиться еще один контрольный мазок после второго менструального цикла.
Таким образом, лечение гонококкового уретрита на дому обычно не представляет особых трудностей. Однако в ряде случаев все же рекомендуется госпитализация. Чаще всего она необходима для более тщательного контроля за лечением. В домашних условиях больной может не заметить вовремя ухудшения своего состояния.
Госпитализация рекомендуется в следующих случаях: - тотальный гонококковый уретрит у мужчин (в отличие от переднего он характеризуется более тяжелым состоянием);
- экстрагенитальные острые формы гонококковой инфекции (фарингит, конъюнктивит, проктит);
- гонококковый сальпингит (воспаление маточных труб) или пельвиоперитонит (воспаление брюшины в малом тазу) у женщин;
- гонококковый простатит (воспаление предстательный железы) и орхит (воспаление яичек) у мужчин;
- диссеминированная гонококковая инфекция (эндокардит, миокардит, менингит, артрит, обильные кожные высыпания);
- бленнорея (поражение глаз) у детей, заразившихся гонореей от матери при родах.
В этих случаях речь идет либо о более тяжелых формах течения болезни, либо о ее осложнениях. Сильно возрастает риск таких необратимых последствий как стерильность, деформация суставов,
слепота, а иногда даже создается угроза для жизни. В связи с этим надлежащий уход могут обеспечить только врачи в больничных условиях.
Самолечение гонореи на дому без обращения к специалисту чаще всего заканчивается хронизацией инфекции. Ни средства народной медицины, ни самостоятельный подбор антибиотика обычно не искореняют инфекцию окончательно. Они могут лишь убрать симптомы болезни. Тогда пациент считает, что вылечился, и уже не обращается к врачу. Проблема в том, что в будущем такая запущенная гонорея будет обостряться снова и снова, ее лечение потребует уже больше времени и сил, а риск осложнений сильно возрастет.
Передается ли гонорея через презерватив?
![]()
В настоящее время презервативы являются наиболее простым и доступным способом защиты от
заболеваний, передающихся половым путем. Существует множество исследований, доказывающих, что это средство эффективно против всех бактериальных и большинства вирусных инфекций. Гонококки, вызывающие гонорею, являются бактериями. Они имеют сравнительно крупные размеры (
по сравнению, например, с вирусами) и не способны проникать сквозь микроскопические поры латекса, из которого изготовлен презерватив. Таким образом, можно утверждать, что гонорея через презерватив не передается.
Тем не менее, есть два важных исключения, о которых необходимо знать пациенту. Во-первых, презервативы высокоэффективны в защите от гонореи только при правильном использовании. В большинстве случаев люди, утверждающие, что заразились через презерватив, попросту не умели им правильно пользоваться.
Чтобы добиться максимальной защиты от инфекции нужно соблюдать следующие правила: - Соблюдение срока годности. На каждой упаковке презерватива обязательно указан срок годности. Если он превышен, то смазка внутри начинает высыхать, а латекс теряет эластичность. Из-за этого при использовании повышается риск разрыва. Даже если презерватив не рвется, в нем появятся микротрещины, которые больше обычных пор. Через них уже могут проникнуть гонококки.
- Использование при любом половом контакте. Гонококки способны поражать не только слизистую оболочку мочевыводящих путей, но и другие ткани (правда, с меньшей вероятностью). Поэтому презерватив следует использовать также при орогенитальном и аногенитальном контакте. Однако в этих случаях риск его разрыва повышается до 3 – 7%.
- Правильное вскрытие упаковки. Плотная на вид упаковка презерватива на деле легко вскрывается руками. Для этого необходимо рвать ее со стороны ребристой поверхности либо в специально указанном месте. Вскрытие острыми предметами (ножи, ножницы) или зубами могут привести к случайному повреждению самого латекса.
- Правильное надевание. При надевании презерватива половой член должен находиться в состоянии эрекции. В противном случае он впоследствии будет сползать и образовывать складки, а в процессе полового акта повысится риск разрыва.
- Выпускание воздуха. При надевании презерватива необходимо зажать пальцами специальную полость на его верхушке, чтобы из нее вышел воздух. Эта полость предназначена для сбора спермы после эякуляции (семяизвержения). Если не выпустить из нее воздух заранее, высок риск разрыва.
- Использование на протяжении всего акта. Презерватив следует надевать еще на этапе предварительных ласк, перед тем как произойдет первый контакт партнера с зараженной слизистой оболочкой. После окончания полового акта презерватив выбрасывают, а пенис обмывают теплой водой для удаления остатков спермы.
Вторым важным моментом, объясняющим возможность заражения гонореей, является то, что презервативы предохраняют лишь от передачи гонококковой инфекции, локализованной в мочеиспускательном канале. Именно эту область покрывает латекс во время полового контакта. Однако существует и ряд других форм гонореи.
Презерватив не защищает от следующих форм гонококковой инфекции: - гонококковый конъюнктивит (воспаление слизистой оболочки глаза);
- фарингит (поражение слизистой оболочки глотки);
- поражение кожи.
Во всех этих случаях гонококки локализуются в других зонах. При этом никаких симптомов болезни может не быть. Порой пациент сам не знает о том, что помимо уретрита (
воспаления мочеиспускательного канала) инфекция есть еще где-либо. Половой контакт с таким пациентом чреват тем, что гонококки попадут на незащищенные слизистые оболочки партнера из других мест. Презерватив при этом может быть использован по всем правилам, но все равно не предотвратит заражения. Правда, такие случаи встречаются очень редко. Дело в том, что при нетипичной локализации гонококки становятся менее заразными. Они хуже размножаются на непривычных клетках. Поэтому передача инфекции таким путем все же маловероятна.
В целом же правильное использование презерватива дает практически стопроцентную гарантию защиты от гонореи. Все же врачи рекомендуют пациентам с этим заболеванием воздерживаться от половых контактов до полного выздоровления.
Передается ли гонорея через поцелуй?
![]()
Гонококковая инфекция чаще всего локализуется в уретре (
мочеиспускательном канале) и на слизистой оболочке половых органов. В этом случае передача болезни через поцелуй невозможна, так как возбудителя нет ни в ротовой полости, ни в слюне. Однако существуют и нетипичные формы этого заболевания, при которых поражаются и другие органы и системы. Одной из таких форм является фарингеальная гонорея или гонококковый фарингит.
При данном заболевании гонококки колонизируют слизистую оболочку глотки и, реже, ротовой полости. Тогда при поцелуе теоретически возможна передача возбудителя партнеру. Однако шанс такого заражения на практике крайне мал.
Передача фарингеальной гонореи через поцелуй маловероятна по следующим причинам: - Гонококки в глотке находятся в непривычных условиях. Лучше всего для их размножения подходит слизистая оболочка уретры, которая отличается по строению от слизистой рта и глотки. Из-за этого количество гонококков меньше, они ослабевают, и вероятность заражения снижается.
- Иммунитет человека также играет значительную роль при данной форме гонореи. Вероятность заражения несколько выше, если у больного иммунитет ослаблен. В этом случае организм плохо борется с микробом, и гонококки активизируются. Но для заражения иммунитет должен быть ослаблен и у второго человека, который целует больного. Иначе гонококк попросту не приживется на его слизистой оболочке.
- Для гонококков лучше подходит слизистая оболочка глотки, нежели ротовой полости. При поцелуе же чаще передаются инфекции, локализующиеся выше.
Таким образом, опасность заражения гонореей через поцелуй крайне мала. Для передачи инфекции на слизистую оболочку рта другого человека должно быть соблюдено слишком много условий. При так называемом «социальном» поцелуе (
не рот в рот), когда не происходит прямого обмена жидкостями, гонорея передаться не может вовсе. Даже большое количество возбудителей, попавших на кожу, быстро погибнет. Здоровый кожный барьер в норме для гонококков непроницаем.
Как лечить гонококковый конъюнктивит?
![]()
Гонококковый конъюнктивит (
гонобленнорея) представляет собой специфическое воспаление слизистой оболочки глаз, вызванное микробом Neisseria Gonorrhoeae. У взрослых гонорея локализуется чаще всего в пределах мочеполовой системы. А вот у новорожденных чаще встречается именно поражение глаз. Инфицирование происходит при прохождении ребенка по родовым путям, если у матери есть гонококковая инфекция.
Лечение такого конъюнктивита следует начинать еще до появления первых симптомов. Если врачам известен диагноз матери, но полностью искоренить инфекцию до родов не удалось, необходимо провести специальную профилактику. Для этого сразу после рождения ребенка в глаза капают препараты, уничтожающие возбудителя болезни.
Для профилактики гонобленнореи применяются следующие средства: - нитрат серебра 1% (капли);
- тетрациклиновая мазь 1%;
- эритромициновая мазь 1%;
- сульфацетамид 20% (раствор).
Все эти препараты используются разово. В каждый глаз капается по 1 капле, либо закладывается мазь. Вероятность развития болезни после такой профилактики многократно снижается. Если же профилактика не проводилась либо оказалась неэффективной, то на 2 – 3 сутки появляются симптомы болезни. Тогда тактика лечения будет другой. На первый план выходит антибиотикотерапия и локальная обработка слизистой оболочки глаза.
Антибиотики для лечения гонококкового конъюнктивита
| Название препарата | Рекомендуемая доза | Особые указания |
| Цефазолин | Раствор 133 мг/мл по 1 капле каждые 2 – 3 часа. | Лечение длится 3 – 4 недели. После уменьшения симптомов и до конца курса препарат капают 3 – 4 раза в сутки. |
| Цефтазидим | Раствор 50 мг/мл по 1 капле каждые 2 – 4 часа. |
| Офлоксацин | Мазь 0,3% закладывается каждые 2 – 4 часа. |
| Ципрофлоксацин | Мазь или раствор по 0,3%, закладывается каждые 2 – 3 часа. |
| Цефтриаксон | Внутримышечная инъекция, делается однократно.
Взрослым – 1 г.
Детям с массой до 45 кг дозу уменьшают до 125 мг.
Новорожденным – 25 – 50 мг на 1 кг веса тела (но не более 125 мг в сутки), в течение 2 – 3 суток. | Точную дозу для детей определяет только лечащий врач. |
Помимо антибиотиков необходимо использовать средства для локальной дезинфекции. Они снизят вероятность присоединения других инфекций и ускорят выздоровление. При поражении роговицы необходимо добавить и другие лекарственные средства. Наиболее эффективны – Ретинола ацетат (
раствор 3,44% 3 раза в сутки) или Декспантенол (
мазь 5% 3 раза в сутки).
При интенсивном подтекании гноя его необходимо смывать. Для этого можно использовать перманганат калия (
марганцовка) 0,2% либо нитрофурал (
фурацилин) в виде 0,02% раствора.
В целом лечением гонококкового конъюнктивита как у детей, так и у взрослых, должен заниматься врач-офтальмолог. При сопутствующей другой локализации инфекции (
обычно - уретрит) необходима консультация дерматовенеролога. Самолечение может привести к дальнейшему распространению процесса на другие структуры глаза, что чревато необратимой потерей зрения.
Симптомы гонореи
Гонокковый конъюнктивит
Диагностика гонореи
Лечение гонореи
Лечение гонорейного баланопостита





 Гонорейный бартолинит – воспаление бартолиновой железы расположенной в задней трети больших половых губ и имеющих выводные протоки, открывающиеся во внешнюю среду у основания больших половых губ. Их воспаление сопровождается резкой болезненностью, выраженной воспалительной реакцией и отечностью соответствующей области.
Гонорейный бартолинит – воспаление бартолиновой железы расположенной в задней трети больших половых губ и имеющих выводные протоки, открывающиеся во внешнюю среду у основания больших половых губ. Их воспаление сопровождается резкой болезненностью, выраженной воспалительной реакцией и отечностью соответствующей области. Гонорея или триппер является одним из самых распространенных венерических заболеваний на планете. Гонорея вызывается особой бактерией – гонококком. Гонококк является кислотоустойчивым микроорганизмом, то есть его клеточная стенка способна защитить его от воздействия нормальной кислой среды половых путей женщины. Особенность клеточной стенки гонококка такова, что он способен формировать антитела различного класса в крови (IgG, IgM, IgA). Причем гонококк формирует особое состояние организма человека, при котором повторное инфицирование происходит легче, чем первое. Высокие титры антител против гонококковой инфекции могут сохраняться в крови достаточно длительное время.
Гонорея или триппер является одним из самых распространенных венерических заболеваний на планете. Гонорея вызывается особой бактерией – гонококком. Гонококк является кислотоустойчивым микроорганизмом, то есть его клеточная стенка способна защитить его от воздействия нормальной кислой среды половых путей женщины. Особенность клеточной стенки гонококка такова, что он способен формировать антитела различного класса в крови (IgG, IgM, IgA). Причем гонококк формирует особое состояние организма человека, при котором повторное инфицирование происходит легче, чем первое. Высокие титры антител против гонококковой инфекции могут сохраняться в крови достаточно длительное время. Экспресс-тесты просты, их можно применять дома в экстренном случае. Внешне похожи на тест для определения беременности. Чтение результатов происходит точно также: одна полоска – результат отрицательный (нет гонорейной инфекции), а две полоски – результат положительный (наличие гонорейной инфекции). Экспресс-тесты на гонорею довольно чувствительны и специфичны. При этом используется метод встречного электрофореза. При проведении такого встречного электрофореза происходит слияние антигенов гонококка и антител, содержащихся в специальной сыворотке. В результате образуется комплекс антиген + антитело, который окрашивает вторую полоску экспресс-теста.
Экспресс-тесты просты, их можно применять дома в экстренном случае. Внешне похожи на тест для определения беременности. Чтение результатов происходит точно также: одна полоска – результат отрицательный (нет гонорейной инфекции), а две полоски – результат положительный (наличие гонорейной инфекции). Экспресс-тесты на гонорею довольно чувствительны и специфичны. При этом используется метод встречного электрофореза. При проведении такого встречного электрофореза происходит слияние антигенов гонококка и антител, содержащихся в специальной сыворотке. В результате образуется комплекс антиген + антитело, который окрашивает вторую полоску экспресс-теста. Для исследования под микроскопом производят забор отделяемого мочеиспускательного канала, влагалища, канала шейки матки, прямой кишки. При этом перед забором биологического материала необходимо прекратить прием антибиотиков минимум за 4-5 дней, в течение 3-4 часов перед забором проб воздержаться от мочеиспускания. Мазки берут в двух экземплярах. Первые экземпляры данных мазков окрашивают метиленовым синим, бриллиантовым зеленым. Наиболее распространен метод окраски метиленовым синим. При этом гонококки окрашиваются в интенсивно синий цвет на фоне бледно-голубой цитоплазмы лейкоцитов. Гонококки могут находиться внутри лейкоцитов или снаружи. Окраска бриллиантовым зеленым дает более сильный контраст между лейкоцитами и гонококками, окрашивая более интенсивно гонококки. Оба этих вида окраски служат ориентировочными, выявляя кокки вообще. Поэтому после выявления кокков, в мазке, окрашенном метиленовым синим, или бриллиантовым зеленым, проводят окраску второго экземпляра мазка по способу Грама. В результате такого метода гонококки окрашиваются в ярко-розовый цвет. Диагноз гонореи ставится только при обнаружении гонококков в мазке, окрашенном по Граму. Окраска метиленовым синим применяется для лучшего выявления кокков, а окраска по Граму применяется для дифференцировки именно гонококков.
Для исследования под микроскопом производят забор отделяемого мочеиспускательного канала, влагалища, канала шейки матки, прямой кишки. При этом перед забором биологического материала необходимо прекратить прием антибиотиков минимум за 4-5 дней, в течение 3-4 часов перед забором проб воздержаться от мочеиспускания. Мазки берут в двух экземплярах. Первые экземпляры данных мазков окрашивают метиленовым синим, бриллиантовым зеленым. Наиболее распространен метод окраски метиленовым синим. При этом гонококки окрашиваются в интенсивно синий цвет на фоне бледно-голубой цитоплазмы лейкоцитов. Гонококки могут находиться внутри лейкоцитов или снаружи. Окраска бриллиантовым зеленым дает более сильный контраст между лейкоцитами и гонококками, окрашивая более интенсивно гонококки. Оба этих вида окраски служат ориентировочными, выявляя кокки вообще. Поэтому после выявления кокков, в мазке, окрашенном метиленовым синим, или бриллиантовым зеленым, проводят окраску второго экземпляра мазка по способу Грама. В результате такого метода гонококки окрашиваются в ярко-розовый цвет. Диагноз гонореи ставится только при обнаружении гонококков в мазке, окрашенном по Граму. Окраска метиленовым синим применяется для лучшего выявления кокков, а окраска по Граму применяется для дифференцировки именно гонококков. Чувствительность данного метода очень вариабельна и составляет 40-86%. Такой разброс связан с тем, что имеются различные подвиды гонококков, некоторые из которых не окрашиваются данным методом. Специфичность же метода довольно высока и доходит до 92%. Также при изучении окрашенных мазков под микроскопом решающее значение имеет квалификация врача-лаборанта. Данный метод является широко распространенным ввиду его доступности, простоты, быстроты и дешевизны.
Чувствительность данного метода очень вариабельна и составляет 40-86%. Такой разброс связан с тем, что имеются различные подвиды гонококков, некоторые из которых не окрашиваются данным методом. Специфичность же метода довольно высока и доходит до 92%. Также при изучении окрашенных мазков под микроскопом решающее значение имеет квалификация врача-лаборанта. Данный метод является широко распространенным ввиду его доступности, простоты, быстроты и дешевизны. Бактериологический или культуральный метод принято считать «золотым стандартом» в выявлении различных инфекционных заболеваний, в том числе гонореи. Суть данного метода состоит в том, что отделяемое слизистых мочеполового тракта высевают на специальные питательные среды и помещают в инкубатор с условиями, пригодными для роста колоний гонококка (высокое содержание углекислого газа 20-23%, температура 37° С). Используется специальная среда, на которой лучше всего растет именно гонококк. Спустя некоторое время (3-7 суток) проверяют выросли ли колонии гонококка. Если колонии выросли, то это является несомненным результатом наличия гонококковой инфекции в организме. Огромный плюс данного метода практически стопроцентная специфичность и отсутствие ложноположительных результатов. Ложноположительный результат – это такой результат, при котором выявлены микроорганизмы там, где их нет. Чувствительность культурального метода также высока и варьирует в пределах 90-98%.
Бактериологический или культуральный метод принято считать «золотым стандартом» в выявлении различных инфекционных заболеваний, в том числе гонореи. Суть данного метода состоит в том, что отделяемое слизистых мочеполового тракта высевают на специальные питательные среды и помещают в инкубатор с условиями, пригодными для роста колоний гонококка (высокое содержание углекислого газа 20-23%, температура 37° С). Используется специальная среда, на которой лучше всего растет именно гонококк. Спустя некоторое время (3-7 суток) проверяют выросли ли колонии гонококка. Если колонии выросли, то это является несомненным результатом наличия гонококковой инфекции в организме. Огромный плюс данного метода практически стопроцентная специфичность и отсутствие ложноположительных результатов. Ложноположительный результат – это такой результат, при котором выявлены микроорганизмы там, где их нет. Чувствительность культурального метода также высока и варьирует в пределах 90-98%.
 Гонорея – это инфекционное заболевание, потому и лечение основано на применении антибактериальных препаратов.
Гонорея – это инфекционное заболевание, потому и лечение основано на применении антибактериальных препаратов.




































